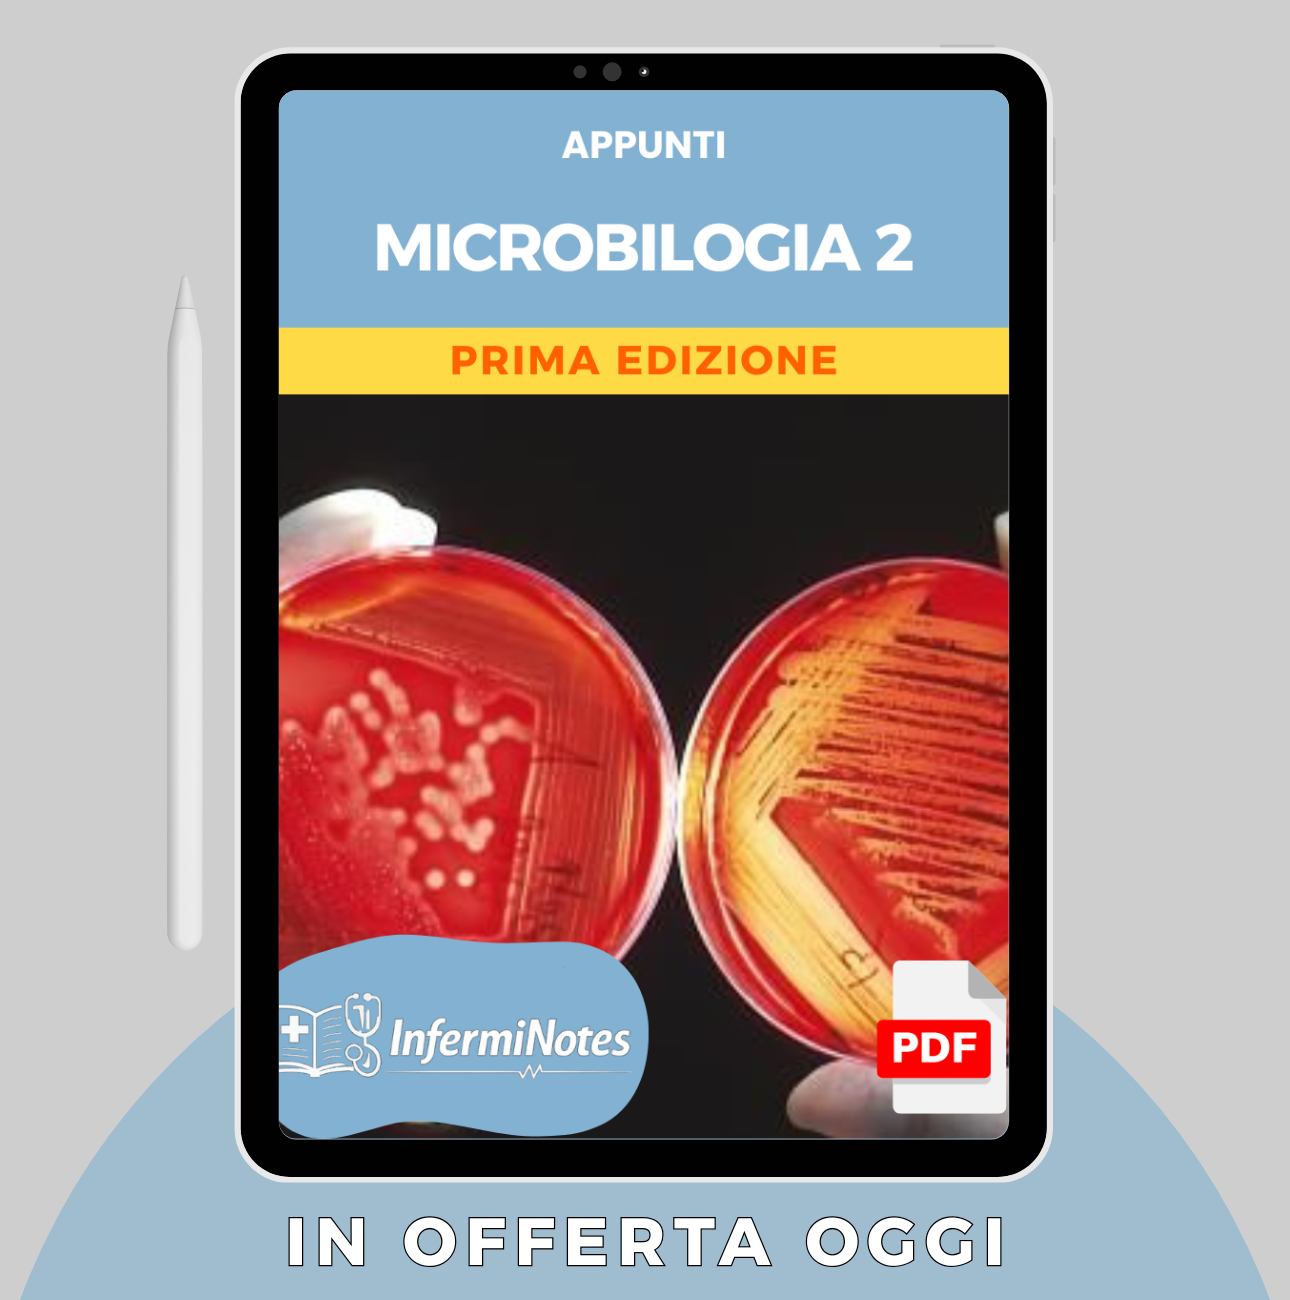
Microbiologia 2

Perchè scegliere i nostri appunti?
Grazie a un approccio pratico e riassunti sintetici, puntiamo a semplificare l'apprendimento e a colmare le lacune in farmaceutica, offrendo un supporto continuo per il successo accademico e professionale.
| InfermiNotes | libri | |
|---|---|---|
| Costo | ||
| Benefit | ||
| Già Riassunto | ||
| Semplici |
I nostri studenti soddisfatti! 🔥
Appunti Singole Materie
Acquista 4 appunti e il quinto te lo regaliamo noi 🎁
Acquista 4 appunti e il quinto te lo REGALIAMO noi! 🎁
Acquista 4 appunti e il quinto te lo REGALIAMO noi! 🎁
Acquista 4 appunti e il quinto te lo REGALIAMO noi! 🎁
Acquista 4 appunti e il quinto te lo REGALIAMO noi! 🎁
Acquista 4 appunti e il quinto te lo REGALIAMO noi! 🎁
Acquista 4 appunti e il quinto te lo REGALIAMO noi! 🎁
Acquista 4 appunti e il quinto te lo REGALIAMO noi! 🎁
Acquista 4 appunti e il quinto te lo REGALIAMO noi! 🎁
Acquista 4 appunti e il quinto te lo REGALIAMO noi! 🎁
Acquista 4 appunti e il quinto te lo REGALIAMO noi! 🎁
Acquista 4 appunti e il quinto te lo REGALIAMO noi! 🎁
Acquista 4 appunti e il quinto te lo REGALIAMO noi! 🎁
Acquista 4 appunti e il quinto te lo REGALIAMO noi! 🎁
Acquista 4 appunti e il quinto te lo REGALIAMO noi! 🎁
Acquista 4 appunti e il quinto te lo REGALIAMO noi! 🎁
Acquista 4 appunti e il quinto te lo REGALIAMO noi! 🎁
InfermiNotes📚
Siamo un team specializzato nell'aiutare studenti e professionisti di farmaceutica a ottimizzare il loro tempo di studio e ad affrontare gli esami con sicurezza. Forniamo appunti strategici, aggiornati e di alta qualità, che coprono tutte le materie di Farmaceutica, ideati per rendere la preparazione più efficiente.